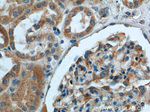
GHDC Antibody in Immunohistochemistry (Paraffin) (IHC (P))

Search
Proteintech
GHDC Polyclonal Antibody
{{$productOrderCtrl.translations['antibody.pdp.commerceCard.promotion.promotions']}}
{{$productOrderCtrl.translations['antibody.pdp.commerceCard.promotion.viewpromo']}}
{{$productOrderCtrl.translations['antibody.pdp.commerceCard.promotion.promocode']}}: {{promo.promoCode}} {{promo.promoTitle}} {{promo.promoDescription}}. {{$productOrderCtrl.translations['antibody.pdp.commerceCard.promotion.learnmore']}}
产品信息
26123-1-AP
种属反应
宿主/亚型
分类
类型
抗原
偶联物
形式
浓度
规格
纯化类型
保存液
内含物
保存条件
运输条件
产品详细信息
Immunogen sequence: KAYPEVLAQ GRTARVTLTS PWPRPLPWPG NTLGQVGTPG TKDPRALLLD ALRSPGLRAL EAGTAVELLD VFLGLETDGE ELAGAIAAGN PGAPLRERAA ELREALEQGP RGLALRLWPK LQVVVTLDAG GQAEAVAALG ALWCQGLAFF SPAYAASGGV LGLNLQPEQP HGLYLLPPGA PFIELLPVKE GTQEEAASTL LLAEAQQGKE YELVLTDRAS LTRCRLGDVV RVVGAYNQCP VVRFICRLDQ TLSVRGEDIG EDLFSEALGR AVGQWAGAKL LDHGCVESSI L (140-429 aa encoded by BC022784)
靶标信息
GHDC, also known as LGP1, is a GH3 domain-containing protein that is highly expressed in normal mammary tissues and mammary tumors. GHDC is primarily located in the nuclear envelope. In mouse, its gene is located on chromosome 11 adjacent to the STAT3/5 locus. Little is known of the function of this protein.
仅用于科研。不用于诊断过程。未经明确授权不得转售。
篇参考文献 (0)
生物信息学
蛋白别名: D11lgp1; DL11LGP1; GH3 domain-containing protein; GHDC1; homolog of mouse LGP1; unnamed protein product
基因别名: D11LGP1; D11LGP1E; GHDC; LGP1
UniProt ID: (Human) Q8N2G8, (Mouse) Q99J23
Entrez Gene ID: (Human) 84514, (Mouse) 80860